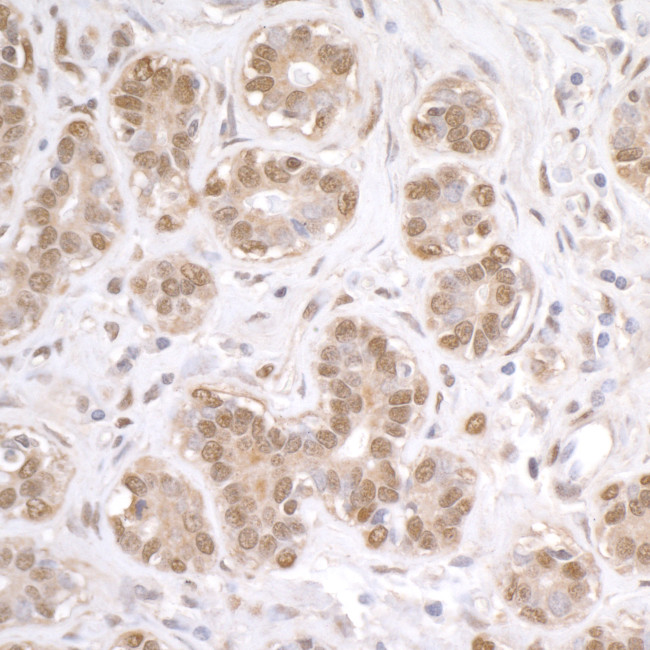
FUS Antibody in Immunohistochemistry (Paraffin) (IHC (P))

Search
Bethyl Laboratories
FUS Polyclonal Antibody
{{$productOrderCtrl.translations['antibody.pdp.commerceCard.promotion.promotions']}}
{{$productOrderCtrl.translations['antibody.pdp.commerceCard.promotion.viewpromo']}}
{{$productOrderCtrl.translations['antibody.pdp.commerceCard.promotion.promocode']}}: {{promo.promoCode}} {{promo.promoTitle}} {{promo.promoDescription}}. {{$productOrderCtrl.translations['antibody.pdp.commerceCard.promotion.learnmore']}}
产品信息
A303-839A
种属反应
宿主/亚型
分类
类型
抗原
偶联物
形式
浓度
规格
纯化类型
保存液
内含物
保存条件
运输条件
产品详细信息
The recommended shelf life for this product is 1 year from date of receipt.
Application Note: For IHC, epitope retrieval with citrate buffer pH 6.0 is recommended for FFPE tissue sections.
Based on 100% sequence identity, this antibody is predicted to react with Bovine
靶标信息
This gene encodes a multifunctional protein component of the heterogeneous nuclear ribonucleoprotein (hnRNP) complex. The hnRNP complex is involved in pre-mRNA splicing and the export of fully processed mRNA to the cytoplasm. This protein belongs to the FET family of RNA-binding proteins which have been implicated in cellular processes that include regulation of gene expression, maintenance of genomic integrity and mRNA/microRNA processing. Alternative splicing results in multiple transcript variants. Defects in this gene result in amyotrophic lateral sclerosis type 6.
仅用于科研。不用于诊断过程。未经明确授权不得转售。
篇参考文献 (0)
生物信息学
蛋白别名: 75 kDa DNA-pairing protein; FUS; fus-like protein; fused in sarcoma; fusion gene in myxoid liposarcoma; fusion, derived from t(12;16) malignant liposarcoma; heterogeneous nuclear ribonucleoprotein P2; hnRNP P2; nuclear RNA-binding protein; Oncogene FUS; Oncogene TLS; pigpen protein; POMp75; Protein pigpen; RNA-binding protein FUS; translocated in liposarcoma; Translocated in liposarcoma protein; unnamed protein product
基因别名: ALS6; altFUS; D430004D17Rik; D930039C12Rik; ETM4; FUS; FUS1; HNRNPP2; POMP75; TLS
UniProt ID: (Human) P35637, (Mouse) P56959
Entrez Gene ID: (Human) 2521, (Mouse) 233908